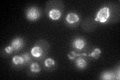
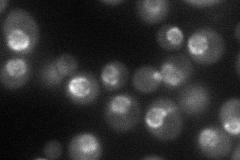
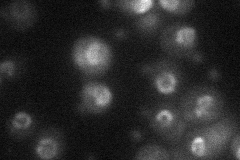
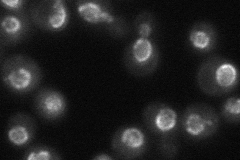

View description
Subunit of the nuclear pore complex (NPC), forms a subcomplex with Nup85p, Nup120p, Nup145p-C, Sec13p, and Seh1p that plays a role in nuclear mRNA export and NPC biogenesis
Localization:
Intensity:
Fold change:
Significance:
-
C’ GFP library in SD
nuclear periphery51.19 -
N' NOP1pr-GFP in SD
nuclear periphery62.6171 -
N' TEF2pr-mCherry in SD
punctate,nuclear periphery25.0125 -
N' NATIVEpr-GFP in SD
punctate,nuclear periphery52.6204 -
N' TEF2pr-VC and Cyto-VN in SD

ER29.6916 -
C’ GFP library in SD+DTT

nuclear periphery41.150.8No -
C’ GFP library in SD+H2O2

nuclear periphery48.180.94No -
C’ GFP library in Starvation Media

nuclear periphery50.550.98No -
C’ GFP library on the background of Pup2-DaMP

N/A -
C’ GFP library on the background of CCT mutant

N/A0N/AYes
